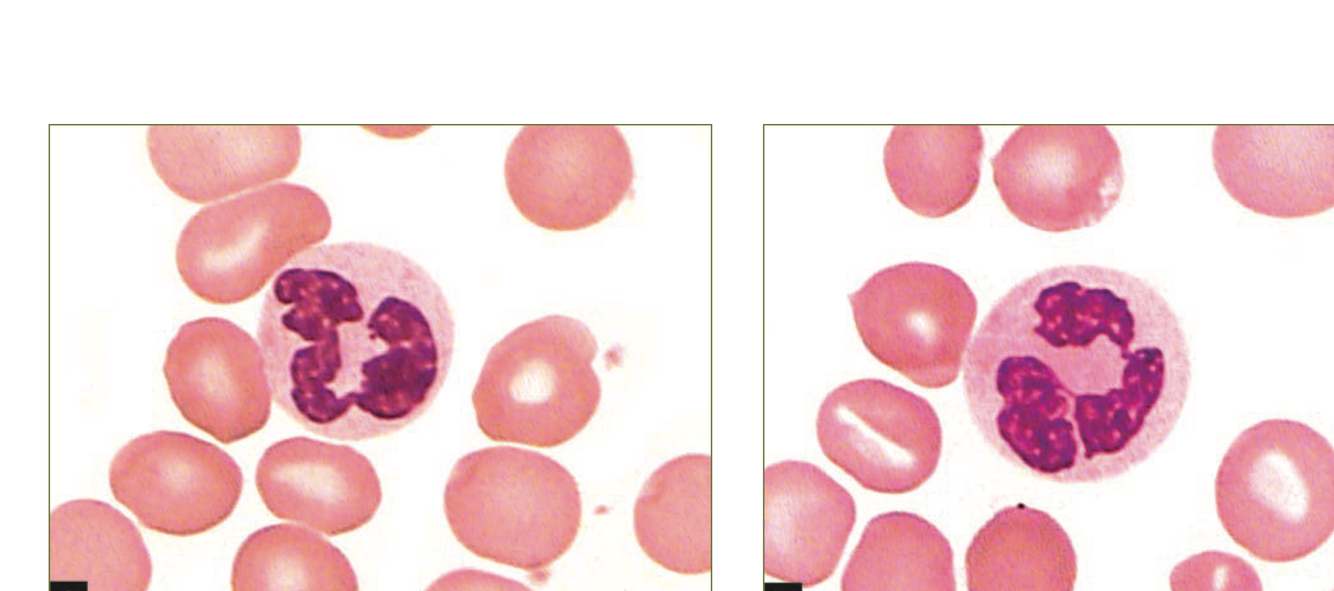
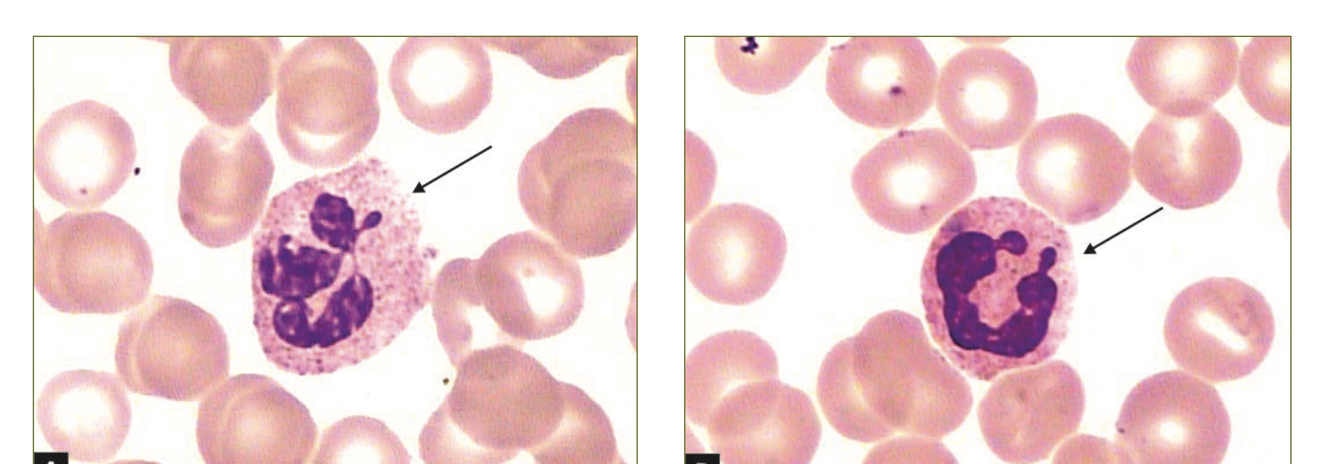
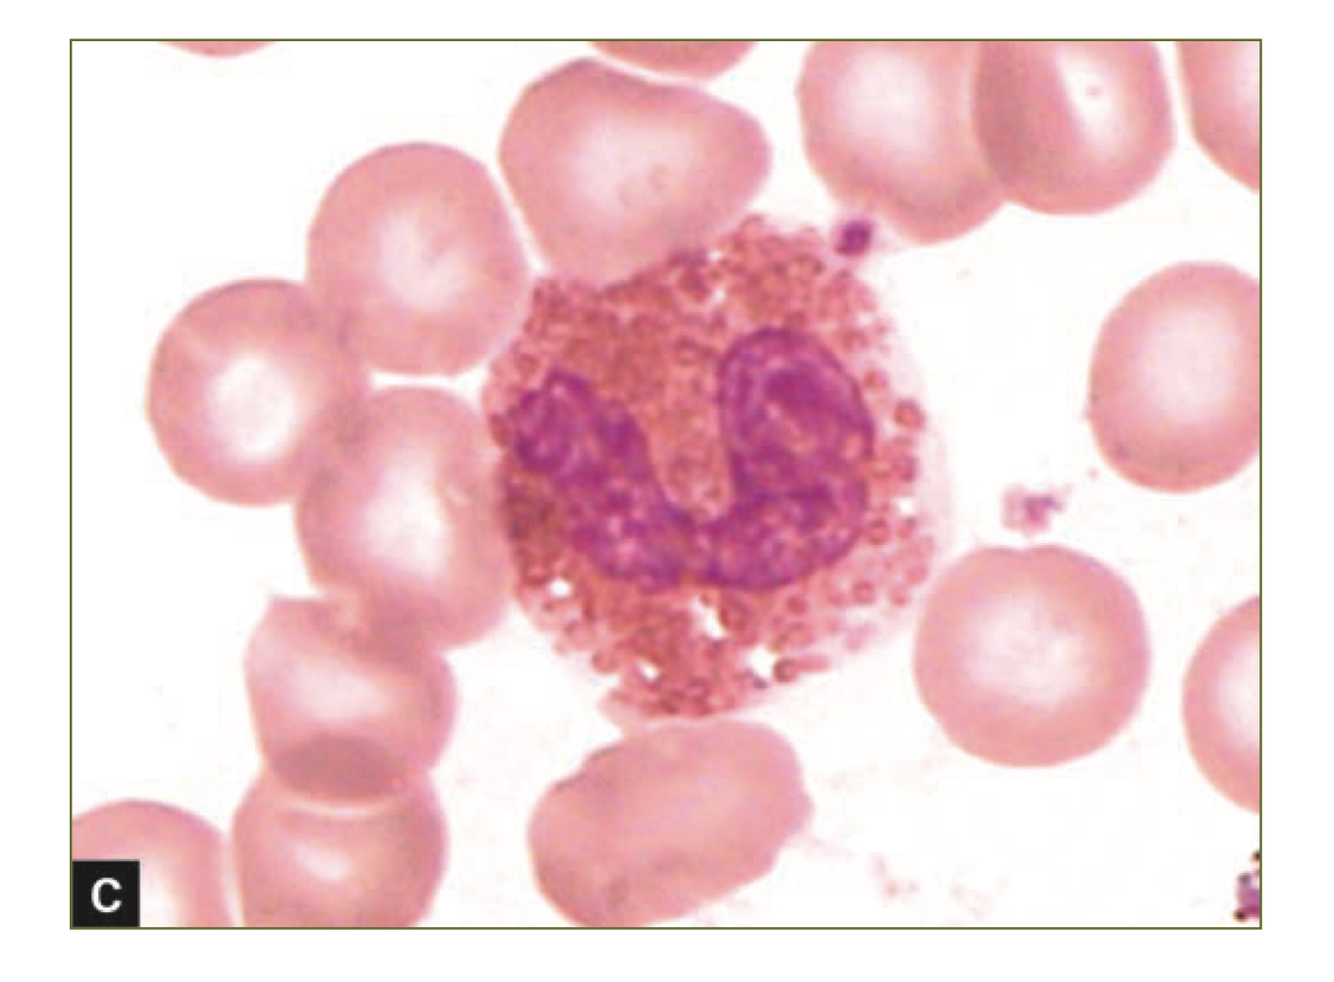
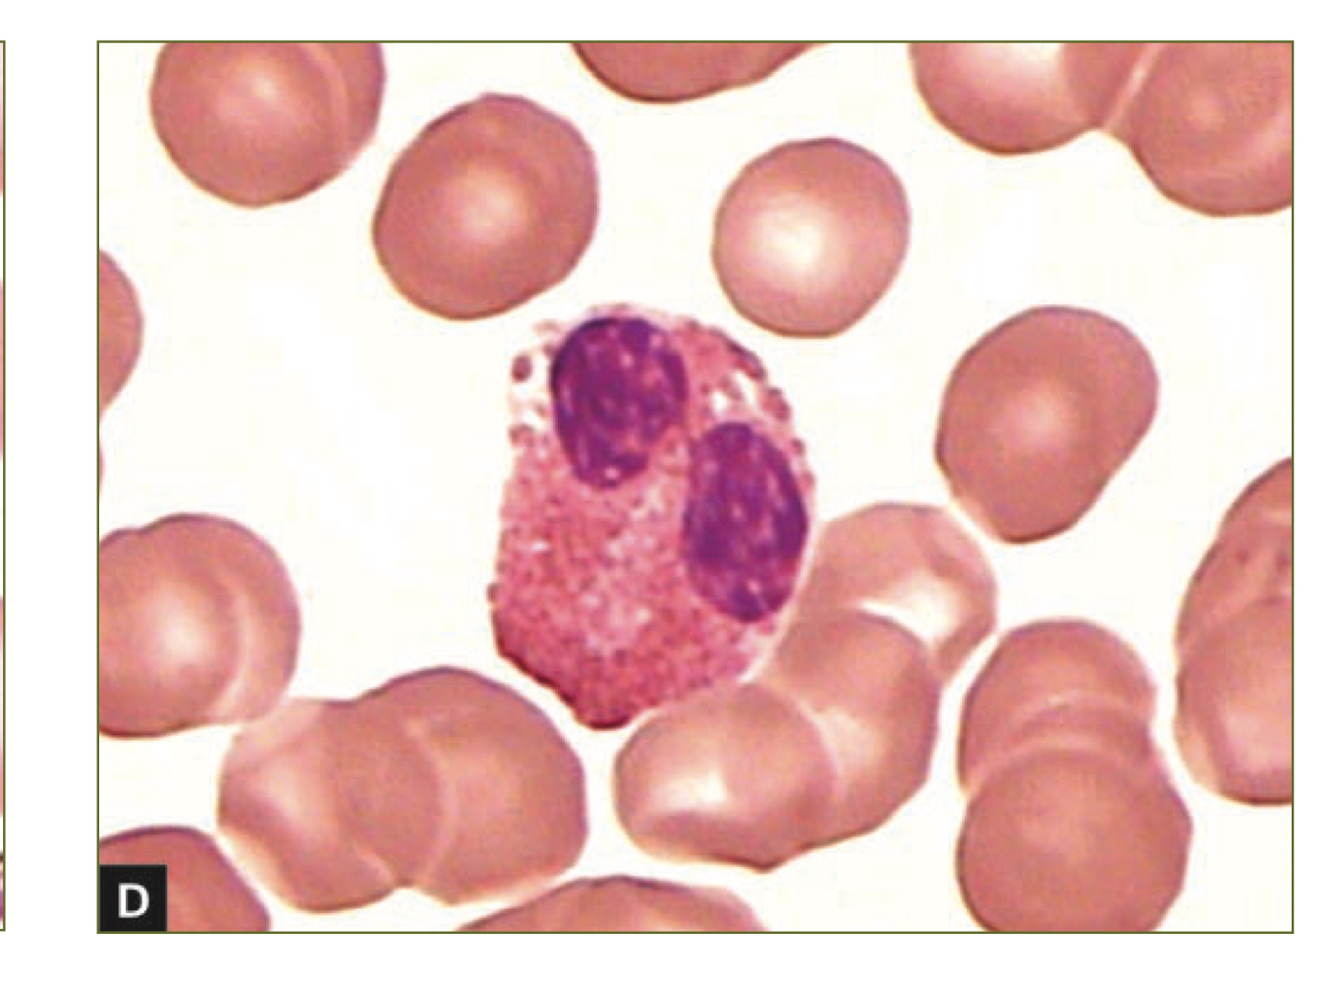
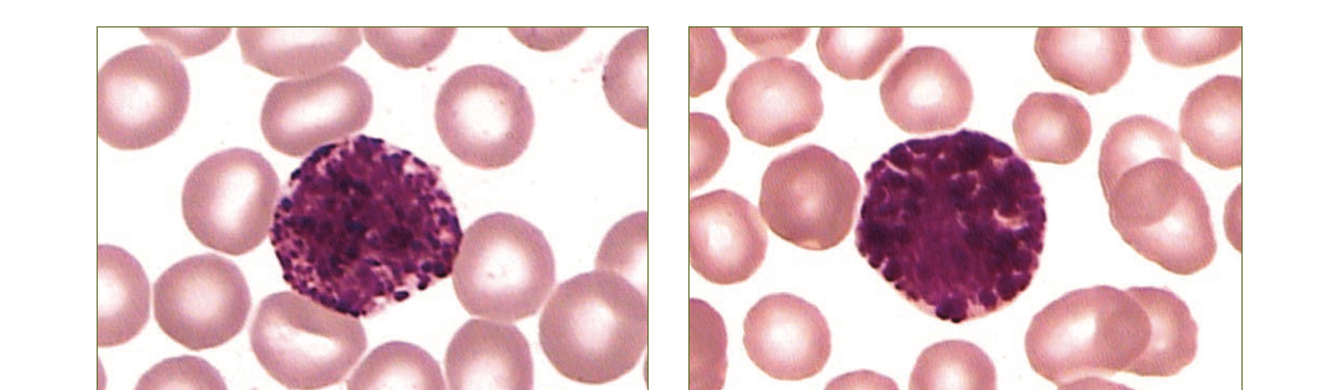
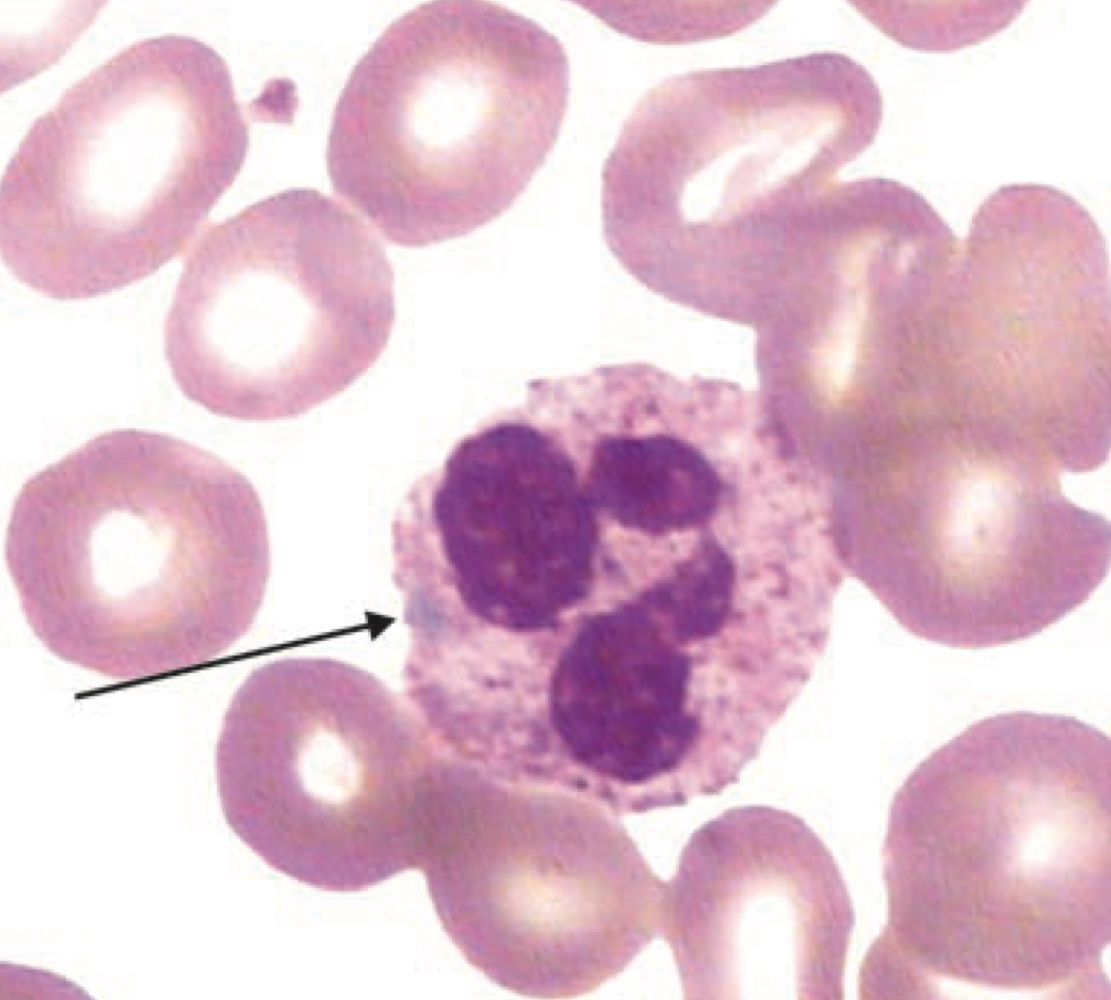

DESCREVA A CÉLULA

MIELOBLASTO
- Tamanho: 10-15 uM
- Citoplasma: Moderadamente basofílico, com presença ou ausência de grânulos
- Núcleo: Redondo a oval, com 2-5 nucléolos e cromatina fina
- Relação N/C: 4/1
- Frequencia MO: 0-2%
Blastos tipo I: Sem granulos
Blastos tipo II: Até 20 grânulos
DESCREVA A CÉLULA

PROMIELÓCITO
- Tamanho: 14-24 uM
- Citoplasma: Basofílico, com presença de granulos grosseiros e azurofílicos, podendo apresentar bastonetes de Auer
- Núcleo: Redondo a oval, com 1-3 nucléolos e cromatina fina, levemente condensada
- Relação N/C: 3/1
- Frequencia MO: 2-5%

DESCREVA A CÉLULA

MIELÓCITO
- Tamanho: 12-18 uM
- Citoplasma: Basofílico leve a creme
- Núcleo: Redondo a oval, excentrico, pode ter um lado achatado. Pode ter uma área clara adjacente (Golgi). Sem nucléolos
- Relação N/C: 2/1
- Frequencia MO: 5-19%

DESCREVA A CÉLULA

METAMIELÓCITOS
- Tamanho: 10-15 uM
- Citoplasma: Rosa pálido a creme com poucos granulos
- Núcleo: Indentado, em forma de rim. Indentação < 50% do comprimento de um nucléolo hipotético. Nucléolos ausentes e cromatina moderadamente condensada
- Relação N/C: 1,5/1
- Frequencia MO: 13-22%
DESCREVA A CÉLULA

BASTONETE
- Tamanho: 10-15 uM
- Citoplasma: Rosa pálido a incolor com abundantes granulos secundários
- Núcleo: Constrito, mas não filamnetoso. Indentação > 50%. Ausencia de nuclelos e cromatina condensada
- Relação N/C: Citoplasma predominante
- Frequencia MO: 17-33%
Blastos tipo I: Sem granulos
Blastos tipo II: Até 20 grânulos
DESCREVA O ACHADO

NEUTRÓFILO HIPERSEGMENTADO
- Sugestivo de anemia megalobástica
- > 5 segmentos nucleares
DESCREVA O ACHADO

NEUTROFILOS BISSEGMENTADOS
- Observados na anomalia Pelger-Huet
DESCREVA O ACHADO
NEUTRÓFILOS HIPOGRANULARES
- SINAL DE MIELODISPLASIA
DESCREVA O ACHADO
CORPÚSCULO DE BARR
Correspondente ao cromossomo X durante a intérfase
DESCREVA O ACHADO

NEUTRÓFILOS COM GRANULAÇÕES TÓXICAS
DESCREVA O ACHADO

NEUTRÓFILO COM VACUOLIZAÇÃO CITOPLASMÁTICA
DESCREVA O ACHADO

MIELÓCITO EOSINÓFILO
DESCREVA O ACHADO
BASTÃO EOSINÓFILO
DESCREVA O ACHADO
EOSINÓFILO
DESCREVA O ACHADO

MIELÓCITO BASÓFILO
DESCREVA O ACHADO
BASÓFILO MADURO
DESCREVA O ACHADO
CORÚSCULO DE DOHLE
- Inclusão leucocitária que ocorre apenas nos neutrófilos e costuma se apresentar na forma oval com coloração azul pálida, frequentemente na periferia da célula
- Representa a liquefação do retículo endoplasmático do neutrófilo
- Associado a quadros infecciosos graves, queimaduras, inflamação, gravidez ou uso de G-CSF
- É muito comum apresentar granulação tóxica ou vacuolização citoplasmática na mesma célula
DESCREVA O ACHADO
CORPUSCULO DE MAY-HEGGLIN
DESCREVA O ACHADO
SÍNDROME DE CHEDIAK-HIGASHI


